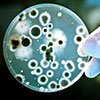
Moisissure sous un microscope

Nos Services
Pré-Achat

L’inspection pré-achat est une étape essentielle afin de vous assurer, par l’entremise d’un professionnel, de l’état général de la propriété convoitée.
Pré-Vente

De plus en plus utilisée par les propriétaires vendeurs, l’inspection prévente vous permet d’approfondir votre connaissance sur votre maison.
Moisissure et amiante
Que ce soit pour un test de moisissure, de bactérie ou d’amiante, nous utilisons différentes techniques de prélèvements afin de vous assurer d’obtenir les résultats maximaux.
Expertise


 1-(844)-744-4666 (sans frais)
1-(844)-744-4666 (sans frais)